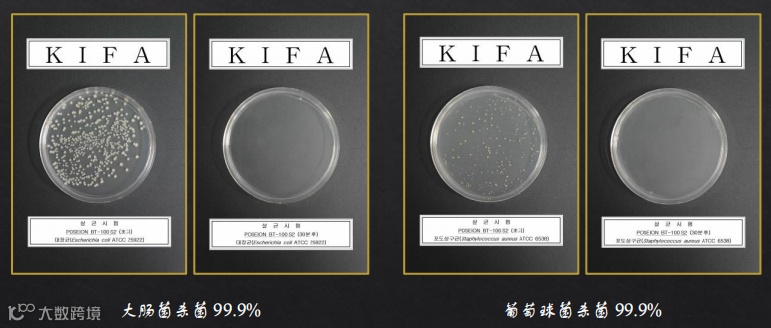
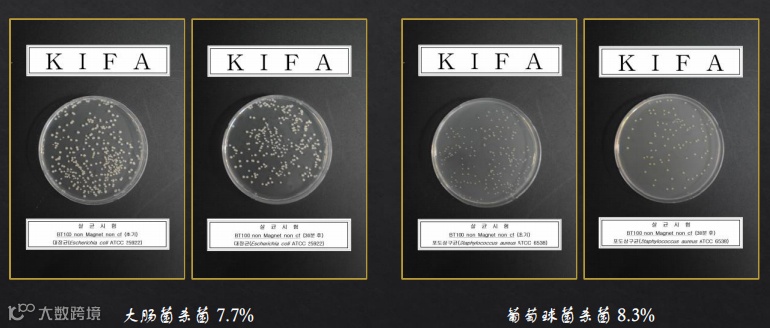
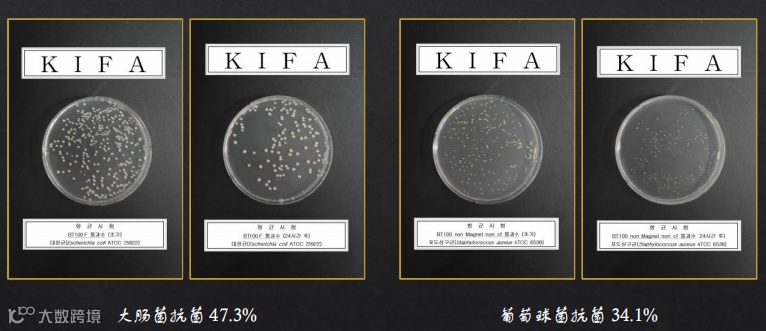
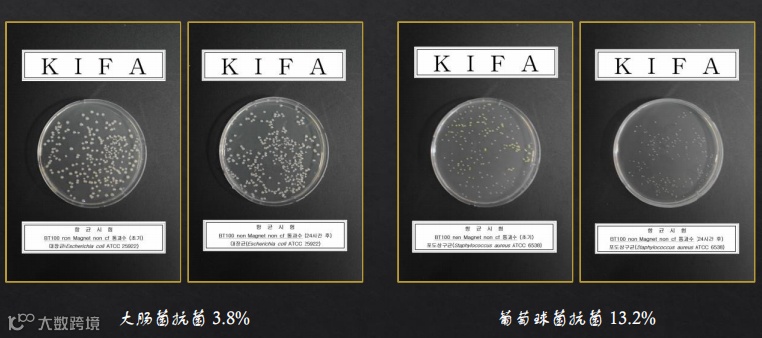

企业介绍
株式会社波赛恩, 意为水之神“波塞冬”。企业始终坚持以人为本,通过不断的挑战和创新,为成为卫浴领域的世界型企业而不断努力。

特点介绍




![]() 抗菌测试
抗菌测试 ![]()

产品功效



产品规格



如想了解更多企业信息,识别专属二维码
申请1:1洽谈


关于KOTRA
大韩贸易投资振兴公社(KOTRA)是1962年成立的具有政府性质的韩国对外贸易促进机构。KOTRA通过推动出口贸易,收集和提供海外市场信息,参加国际展览,开展海外宣传,投资振兴等方面的综合性工作,促进韩国中小企业开拓国际市场,加快向世界迈进的步伐。
HARBIN

扫描二维码
关注我们
微信号 : kotra_harbin


